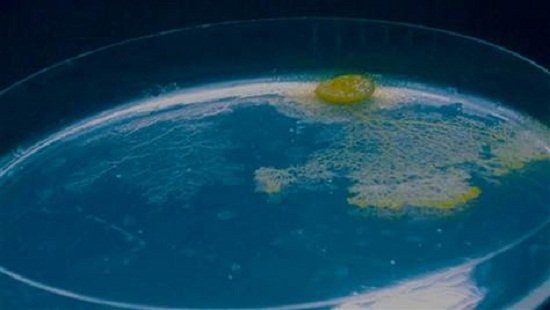

腾讯科学讯(过客/编译)研究人员称,一种粘液菌即使没有大脑也基本上能够记住它曾经在哪里,帮助它能够像现代的机器人一样穿过复杂的障碍物。科学家们补充道,这些发现揭露了古代生物体在进化出复杂的大脑之前如何妥善的解决某些问题。
当黄色的粘液菌移动的时候会留下一道浓厚的半透明粘液,研究人员发现粘液菌把这种胶状痕迹当做一种前行的记忆
粘液菌曾经被认为是一种真菌,但是后来的研究表明这些粘性物是由名为原生生物的微生物组成的混杂群体部分。研究人员研究的这种黄色粘液菌名为多头绒泡菌,它事实上是一种尺寸超过1平方英尺的巨大单细胞,内部含有数百万相同的细胞核。
研究人员查理斯-里德是澳大利亚悉尼大学的一位复杂系统生物学家,他说到:“对于一种单细胞生物体来说,它的能力不断的带给研究人员惊奇,比如说解答迷宫、预期周期性时间以及甚至向我们一样做出不理性的决策。它真的是一种非常奇妙的生物,它正在改变我们对于智力的概念。”
当这种粘液菌移动的时候,它会留下一层半透明的浓厚粘液,而且粘液菌后来会避开这些痕迹。研究人员们认为粘液菌或许把这种胶状痕迹作为一种记忆。里德告诉《生命科学》道:“主要的误解或许在于认为粘液菌和我们一样拥有记忆。我必须要强调的是粘液菌无法像我们一样产生、储存或者回忆记忆,因为它没有大脑甚至也没有神经元。”
里德说到:“当然,我们对于记忆的定义相当广泛,与过去事件相关的信息存储和检索都称之为记忆。”这项研究的作者详细描述了粘液菌把它的痕迹用作它曾经到达那里的一种提醒,里德把它比作《奇幻森林历险记》中的面包痕迹或者希腊神话中提修斯用于逃离弥诺陶洛斯迷宫的线团。
为了探索它们的想法,科学家们对粘液菌进行了测试,测试中粘液菌必须到达位于一块U型障碍物后的含糖食物。类似的问题通常用于机器人测试来了解它们是否能独立自主的穿过复杂的障碍物来抵达期望的目标。
在一些试验中,粘液菌能够探测到它们自己的胶状痕迹。在其它试验中研究人员用额外的凝状物覆盖这一区域来掩盖粘液菌自己的痕迹。当绒泡菌能够探测到它自己的痕迹时,它们平均多到达三次并且速度大约增加了30%。里德称无视于它们自己痕迹的粘液菌耗费了接近十倍的时间在它们已经到达的区域重新探索。
里德说到:“这是第一次在无大脑的生物中证实一种空间记忆系统,而且第一次有证据支持之前未经测试的一个理论,远古时期的原始生物可能使用一种具体化的记忆来解决今天我们复杂大脑所处理的问题。”里德和他的同事们计划继续研究这些粘液痕迹。里德说到:“有可能粘液菌在粘液中留下了完整的信息来与未来的自己或者其它碰巧就在周围的粘液菌交流。”
编辑:quarkqiao
新闻来源:http://tech.qq.com/a/20121011/000033.htm

留言